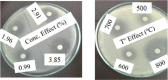

Effects of Sulfur Doping and Temperature on the Energy Bandgap of ZnO Nanoparticles and Their Antibacterial Activities
- PMID: 35382288
- PMCID: PMC8973117
- DOI: 10.1021/acsomega.2c00647
Effects of Sulfur Doping and Temperature on the Energy Bandgap of ZnO Nanoparticles and Their Antibacterial Activities
Abstract
Metal oxide nanoparticles (MO-NPs) are presently an area of intense scientific research, attributable to their wide variety of potential applications in biomedical, optical, and electronic fields. MO-NPs such as zinc oxide nanoparticles (ZnO-NPs) and others have a very high surface-area-to-volume ratio and are excellent catalysts. MO-NPs could also cause unexpected effects in living cells because their sizes are similar to important biological molecules, or parts of them, or because they could pass through barriers that block the passage of larger particles. However, undoped MO-NPs like ZnO-NPs are chemically pure, have a higher optical bandgap energy, exhibit electron-hole recombination, lack visible light absorption, and have poor antibacterial activities. To overcome these drawbacks and further outspread the use of ZnO-NPs in nanomedicine, doping seems to represent a promising solution. In this paper, the effects of temperature and sulfur doping concentration on the bandgap energy of ZnO nanoparticles are investigated. Characterizations of the synthesized ZnO-NPs using zinc acetate dihydrate as a precursor by a sol-gel method were done by using X-ray diffraction, ultraviolet-visible spectroscopy, and Fourier transform infrared spectroscopy. A comparative study was carried out to investigate the antibacterial activity of ZnO nanoparticles prepared at different temperatures and different concentrations of sulfur-doped ZnO nanoparticles against Staphylococcus aureus bacteria. Experimental results showed that the bandgap energy decreased from 3.34 to 3.27 eV and from 3.06 to 2.98 eV with increasing temperature and doping concentration. The antibacterial activity of doped ZnO nanoparticles was also tested and was found to be much better than that of bare ZnO nanoparticles.
© 2022 The Authors. Published by American Chemical Society.
Conflict of interest statement
The authors declare no competing financial interest.
Figures

References
-
- Oskam G.; Penn R. L.; Hu Z.; Searson P. C.. Synthesis and Characterization of Metal Oxide Nanoparticles. Emerging Fields in Sol-Gel Science and Technology; López T. M.; Avnir D.; Aegerter M.; Springer: Boston, MA, 2003.
-
- Yusuf M.Silver Nanoparticles: Synthesis and Applications. Handbook of Ecomaterials; Springer: Cham, Switzerland, 2018; pp 2343–2356.
-
- Chavali M. S.; Nikolova M. P. Metal oxide nanoparticles and their applications in nanotechnology. SN Appl. Sci. 2019, 1, 607.10.1007/s42452-019-0592-3. - DOI
LinkOut - more resources
Full Text Sources